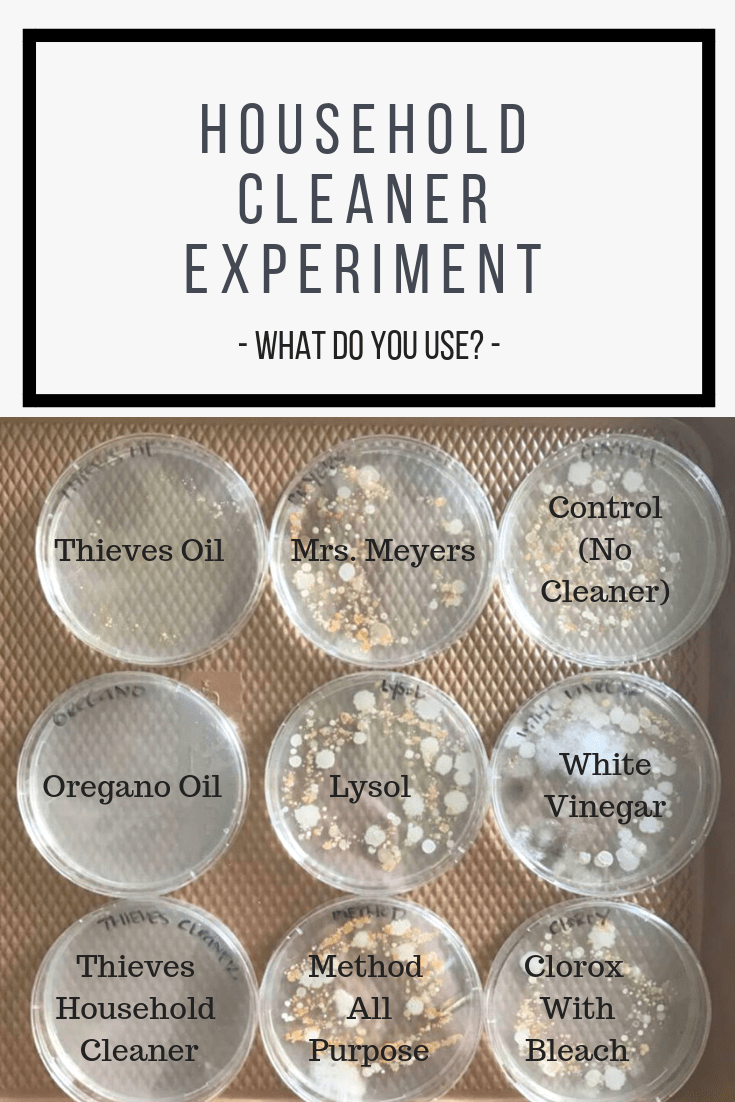
Learn more by clicking the link_ www.reallygreatsite.com (2)

Go to the store and walk down the home cleaning aisle, or maybe there are multiple at your local store. There is a lot to choose from! How do we know what to buy and use in our homes? Is it brand loyalty to something you grew up with in your childhood home? That was my top way of choosing the items I put in my cart until Young Living entered my life and I learned about their line of Thieves cleaning products.
Before I knew about oils, I knew about the power of thieves. It was something that kept coming up, from the local stores who were selling thieves bath bombs to friends talking casually about thieves cough drops being more effective. It all clicked once I started this EO journey and saw the plethora of thieves products and researched the true history behind the blend.
Did you know that thieves is known as the “anti-plague?” This is due to the fact that during the middle ages, people would use the thieves blend to ward off the black plague with success. That’s compelling enough for me to throw it in my shopping cart any day.
Take a look at how Young Living’s Thieves Household Cleaner stacks up against many mainstream brands you may be using right now:
Even better, Young Living’s Household cleaner is so concentrated that one bottle can last up to 6 months or longer, making it cheaper than the cleaner the average person is using off the grocery store shelf.
*Your Thieves Household Cleaner sample in the Starter Kit will make a 16oz glass spray bottle worth of cleaner that you can clean anything in your house with….and it’s safe enough to clean your baby toys or have your toddler help wipe up after you!
16oz Glass Spray Bottle: Purchase Here
Take a second and google the health risks of cleaning products. Scary, right?
The best part is the bottle of cleaner is so versatile that it can replace almost everything under your sink right now. Take a look at some of the ways to be a cleaning mixologist:

Oh and I have saved the best for last…. IT SMELLS LIKE CHRISTMAS!
You’re welcome.
Can’t get enough Thieves?! Purchase an entire Thieves Starter Kit! Take a look below:

Check out the details – Click Here


Leave a comment